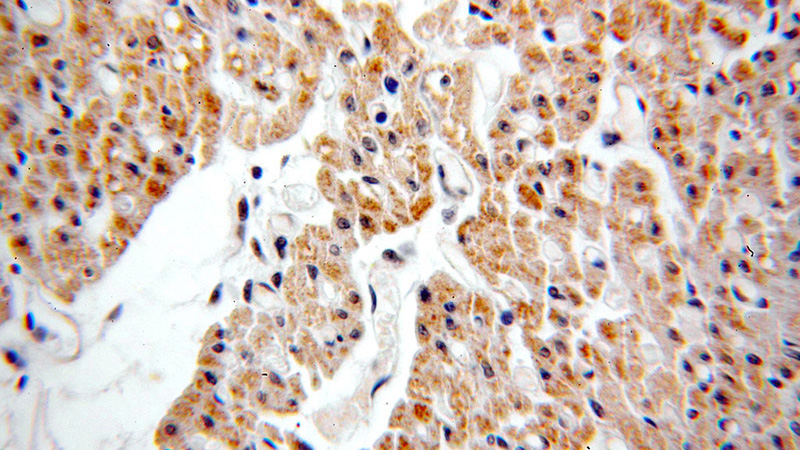
Immunohistochemical of paraffin-embedded human heart using Catalog No:109626(CUL7 antibody) at dilution of 1:50 (under 40x lens)

-
Product Name
CUL7 antibody
- Documents
-
Description
CUL7 Rabbit Polyclonal antibody. Positive WB detected in HEK-293 cells, A431 cells. Positive IHC detected in human heart tissue, human skeletal muscle tissue. Observed molecular weight by Western-blot: 185kd
-
Tested applications
ELISA, WB, IHC
-
Species reactivity
Human, Mouse; other species not tested.
-
Alternative names
CUL 7 antibody; CUL7 antibody; cullin 7 antibody; dJ20C7.5 antibody; KIAA0076 antibody
-
Isotype
Rabbit IgG
-
Preparation
This antibody was obtained by immunization of CUL7 recombinant protein (Accession Number: NM_014780). Purification method: Antigen affinity purified.
-
Clonality
Polyclonal
-
Formulation
PBS with 0.02% sodium azide and 50% glycerol pH 7.3.
-
Storage instructions
Store at -20℃. DO NOT ALIQUOT
-
Applications
Recommended Dilution:
WB: 1:200-1:2000
IHC: 1:20-1:200
-
Validations

HEK-293 cells were subjected to SDS PAGE followed by western blot with Catalog No:109626(CUL7 antibody) at dilution of 1:300

Immunohistochemical of paraffin-embedded human heart using Catalog No:109626(CUL7 antibody) at dilution of 1:50 (under 10x lens)
Immunohistochemical of paraffin-embedded human heart using Catalog No:109626(CUL7 antibody) at dilution of 1:50 (under 40x lens)

Immunohistochemistry of paraffin-embedded human skeletal muscle tissue slide using Catalog No:109626(CUL7 Antibody) at dilution of 1:50 (under 40x lens)
-
Background
The cullin family proteins are scaffold proteins for the Ring finger type E3 ligases, participating in the proteolysis through the ubiquitin-proteasome pathway. Humans express seven cullin proeins: CUL1–3, CUL4A, CUL4B, CUL5, and CUL7. Each cullin protein can form an E3 ligase similar to the prototype Ring-type E3 ligase Skp1-CUL1-F-box complex. The Cullin-RING-finger type E3 ligases are important regulators in early embryonic development, as highlighted by genetic studies demonstrating that knock-out of CUL1, CUL3, or CUL4A in mice results in early embryonic lethality. CUL7 was originally discovered as 185-kDa protein associated with the large T antigen of simian virus 40 (SV40). CUL7-deficient mice exhibit neonatal lethality with reduced size and vascular defects. CUL7 presumably plays a role in the DNA damage response by limiting p53 activity. CUL7 mutations have also been identified in 3-Msyndrome and the Yakuts short stature syndrome, both of which are characterized by pre- and post-natal growth retardation but with relatively normal mental and endocrine functions, suggesting that CUL7 may also be crucial for human placental development.
-
References
- Zhang W, Wang Q, Song P, Zou MH. Liver kinase b1 is required for white adipose tissue growth and differentiation. Diabetes. 62(7):2347-58. 2013.
Related Products / Services
Please note: All products are "FOR RESEARCH USE ONLY AND ARE NOT INTENDED FOR DIAGNOSTIC OR THERAPEUTIC USE"
